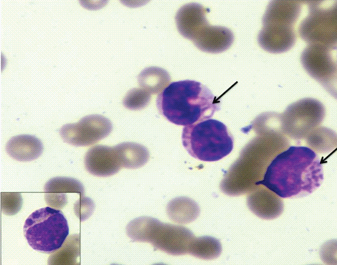

Congenital Acute Myeloid Leukaemia with Pseudo-Chediak-Higashi Like Granules: A Case Report
Vandana Puri1, Sandip Barman2, Pooja Sharma3, Meera Sikka4
1 Assistant Professor, Department of Pathology, University College of Medical Sciences, Delhi, India.
2 Postgraduate, Department of Pathology, University College of Medical Sciences, Delhi, India.
3 Postgraduate, Department of Pathology, University College of Medical Sciences, Delhi, India.
4 Head of Department, Department of Pathology, University College of Medical Sciences, Delhi, India.
NAME, ADDRESS, E-MAIL ID OF THE CORRESPONDING AUTHOR: Dr. Vandana Puri, Assistant Professor, Department of Pathology, University College of Medical Sciences, Delhi, India.
E-mail: drvandanapuri@gmail.com
Congenital leukaemia is a very rare entity comprising 0.8% of all childhood leukaemias. Pseudo-Chediak-Higashi Anomaly (PCHA) in acute leukaemia is a rarely described entity. However, co-existence of congenital myeloid leukaemia with PCHA is a very rare entity and to the best of our knowledge has not been described in literature till date. A full term new-born presented on the 27th day of life with severe gastroenteritis. Complete blood counts and peripheral smear examination revealed leucocytosis with presence of 76% blast cells. Approximately 15% of these blast cells showed presence of pseudo-Chediak-Higashi like granules. The diagnosis of acute myeloid leukaemia was confirmed by flow cytometry. The case report is presented due to its rarity and to highlight the differential diagnosis and clinical implications of this entity.
Coarse granules, Leukaemia, New born, Prognosis
Case Report
A full term new-born, hospital delivered by normal vaginal delivery, presented on the 27th day of life with severe gastroenteritis. No history of haematemesis, respiratory distress, haemoptysis was present. Patient was afebrile. No significant family history was present. On examination he was severely dehydrated. Per abdomen examination revealed hepatomegaly (5cm below right costal margin), splenomegaly (4cm below left costal margin). There were no clinical features suggestive of Down syndrome.
Complete blood counts (Automated haematology analyser LH500) revealed haemoglobin of 7.6gm/dl, a total leucocyte count of 121.7x109/L and platelet count of 297x109/L. Peripheral smear examination showed presence of 76% blasts which were 2-3 times the size of small mature lymphocytes with high nuclear-cytoplasmic ratio, moderate amount of cytoplasm, round to oval nucleus, fine chromatin and 0-1 nucleoli. Approximately 15% of these blast cells showed presence of coarse granules also known as pseudo-Chediak-Higashi like granules [Table/Fig-1]. These granules were not seen in any other type of cells in the peripheral smear. No definite Auer rods were seen. Red cells were predominantly normocytic normochromic. Platelets were reduced.
Wright stained peripheral smear showing blasts with pseudo-Chediak-Higashi granules (×400). Inset showing higher magnification of single blast (×1000).
Cytochemistry revealed that the blasts were positive for Myeloperoxidase (MPO), Sudan Black B (SBB) and negative for Periodic acid-Schiff (PAS). The coarse granules were also positive for MPO and SBB. Flow cytometry from peripheral blood revealed positivity for CD34, HLA-DR, CD117, cMPO, CD33 [Table/Fig-2a,b]. CD10, CD19, CD14, CD64, cCD79a and cCD3 were negative. Bone marrow examination and karyotyping of the patient could not be done as the patient succumbed to his illness on the same day. A final diagnosis of congenital acute myeloid leukaemia with pseudo-Chediak-Higashi like granules was made. The patient was managed for severe gastroenteritis and dehydration.
On flow cytometry, gated blasts revealed positivity for CD34, CD117, HLA DR and CD33.

Flow cytometry revealing positivity for cMPO.

Discussion
Leukaemia occurring in or before the first month of life is known as congenital leukaemia [1]. It is a very rare entity comprising 0.8% of all childhood leukaemia, with an incidence of 4.3- 8.6 per million live births [2]. Pseudo-Chediak-Higashi Anomaly (PCHA) in acute leukaemia is a rarely described entity. It is characterised by the presence of giant granules in leukaemia cells mimicking the granules of Chediak Higashi Syndrome (CHS) [3].
The Criteria Proposed for Diagnosis of Congenital Leukaemia [
2]:
(1) Disease presentation at or shortly after birth (<30 days).
(2) Proliferation of immature white cells.
(3) Infiltration of the cells into extra hematopoietic tissues.
(4) Absence of any other conditions that mimics congenital leukaemia such as Transient Myeloproliferative Disorder (TMD), syphilis and various viral infections.
Most of the paediatric leukaemias are lymphoid in origin. In contrast CL are mostly of myeloid lineage with acute monocytic and myelomonocytic leukaemia being the most prevalent subtypes [4,5]. Patient in our study presented with AML-M2.
Patients with CL usually show signs of hepatosplenomegaly, petechiae, ecchymoses and sepsis and may have firm blue or red nodules in the skin (blueberry muffin) [6]. This patient presented with acute gastroenteritis and hepatosplenomegaly was present. Blood culture was sent at the time of admission. The report came later which demonstrated no growth.
PCHA in congenital leukaemia is a very rare entity. It is characterised by the presence of giant granules in leukaemic cells mimicking the granules of CHS. Granules in CHS are present in all the nucleated blood cells. In this case granules were present only in the blasts thus ruling out Chediak-Higashi syndrome.
Didisheim et al., first reported large, round, eosinophilic granules in leukaemic cells in a case of Acute Promyelocytic Leukaemia (APML) [7]. Van Slyck and Rebuck reported similar granules in leukaemic cells in two patients of acute myelomonocytic leukaemia and coined the term “The pseudo Chediak-Higashi Anomaly of acute leukaemia” [8]. PCHA has been reported in Acute Myeloid Leukaemia (AML), APML, AML of childhood and CML with myelofibrosis [9]. These inclusions have been described as pink azurophilic or having a vacuolated appearance and are myeloperoxidase positive [10]. In our case the granules were azurophilic and myeloperoxidase and Sudan Black positive. Studies have shown frequent CD2 expression in myeloblasts with PCH granules [9]. But in this case CD2 positivity could not be ascertained. Ultrastructurally these granules show electrolucent material with a dense matrix and finger print structures at the periphery [10].
Congenital leukaemia has a very poor prognosis with only 23% surviving beyond two years [11]. However, paediatric AML cases with PCHA have not shown any adverse outcome compared with patients without PCH granules in leukaemic cells [9].
Conclusion
Congenital leukaemia itself is a very rare entity with grave prognosis. Patients with PCHA usually have short survival times due to fulminant infections or refractory DIC. However, co-existence of congenital myeloid leukaemia with PCHA is an extremely rare entity. This case is reported in view of the rarity of the lesions and to make clinicians aware of this entity to make early diagnosis and plan prompt management.
[1]. Perkins SL, Hematopoietic system. In: Gilbert-Barness E (ed)Potter’s pathology of the fetus, infant and child 2007 2nd edPhiladelphiaElsevier:1453-1514. [Google Scholar]
[2]. McCoy JP Jr, Overton WR, Immunophenotyping of congenital leukaemiaCytometry 1995 22:85-88. [Google Scholar]
[3]. Agrawal P, Kumar N, Sharma P, Varma S, Varma N, Pseudo-Chediak-Higashi granules in acute lymphoblastic leukaemia: A Rare EntityIndian Journal of Hematology & Blood Transfusion 2014 30:201-03. [Google Scholar]
[4]. Garewal G, Marwaha RK, Ray R, Singh N, Gupta A, Sarode VR, Congenital acute lymphoblastic leukaemia: Report of a case with unusual immunophenotypeAm J Hematol 1993 44:147-48. [Google Scholar]
[5]. Hanada T, Kanamitsu K, Chayama K, Miyamura T, Kanazawa Y, Muraoka M, A long-term survivor after congenital acute myeloid leukaemia with t(8; 16)(p11; p13)Acta Med Okayama 2016 70:31-35. [Google Scholar]
[6]. Pui CH, Kalwinsky DK, Schell MJ, Mason CA, Mirro J, Dahl GV, Acute non lymphoblastic leukaemia in infants: clinical presentation and outcomeJ Clin Oncol 1988 6:1008-13. [Google Scholar]
[7]. Didisheim P, Trombold JS, Vandervoot RL, Mibishan RS, Acute promyelocytic leukaemia with fibrinogen and factor V deficienciesBlood 1964 23:717-28. [Google Scholar]
[8]. Van Slyck EJ, Rebuck JW, Pseudo-Chediak-Higashi Anomaly in acute leukaemiaAm J Clin Pathol 1974 62:673-78. [Google Scholar]
[9]. Rao S, Kar R, Saxena R, Pseudo Chediak-Higashi Anomaly in acute myelomonocytic leukaemiaIndian J Pathol Microbiol 2009 52:255-56. [Google Scholar]
[10]. Mizushima W, Eguchi M, Sakakibara H, Sugita K, Furukawa T, Kanagawa M, Electron microscopic cytochemistry of pseudo-Chediak-Higashi granules in 5 cases of AMLRinsho Ketsueki 1990 31:799-806. [Google Scholar]
[11]. Bresters D, Reus AC, Veerman AJ, van Wering ER, van der Does-van den Berg A, Kaspers GJ, Congenital leukaemia-the Dutch experience and review of the literatureBr J Hematol 2002 117:513-24. [Google Scholar]